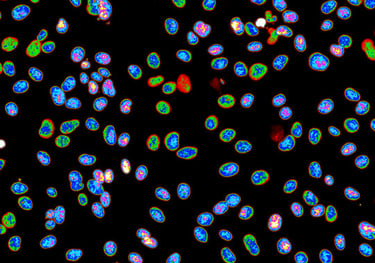
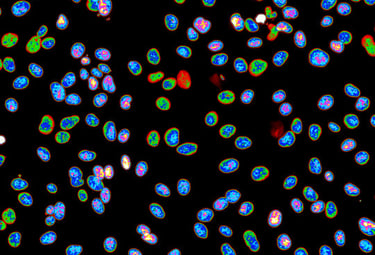
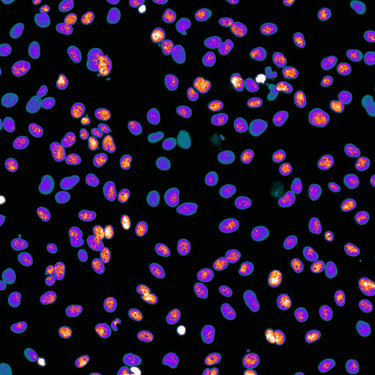
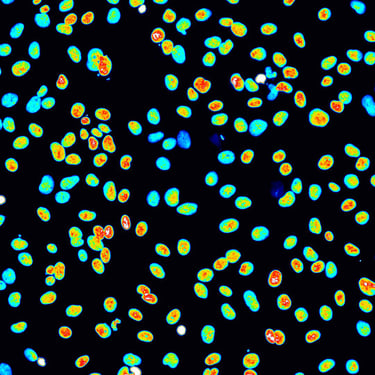

Welcome to Mauvezin Lab
Our research aims to uncover how cancer cells acquire and tolerate genomic instability by dissecting the molecular processes that govern mitosis, autophagy, and chromosome maintenance. Because chromosomal instability is a defining hallmark of tumor progression, understanding how pathways such as replication stress responses, lysosome‑dependent degradation, and autophagy shape cell‑division fidelity allows us to identify the upstream events that destabilize the genome. By integrating these mechanistic insights, our laboratory seeks to reveal new vulnerabilities in cancer cells and pave the way toward more precise CIN‑targeted therapeutic strategies.
Our laboratory in the Department of Biomedicine at the University of Barcelona stands at the interface of two prominent fields in cancer research, autophagy and cell division.
Our Research
Collaborations
We collaborate across basic and translational research to identify drivers of chromosomal instability and advance fundamental discoveries toward therapeutic applications.
Our research is supported by competitive national and international funding, enabling innovative work in genome stability and cancer biology and reinforcing the value of fundamental research as a foundation for future therapies.

Our laboratory studies cancer cell biology with a particular focus on autophagy, cell cycle regulation, and toroidal nucleus biology. We have extensive expertise in the identification and characterization of toroidal nuclei and in autophagy-related experimental approaches.